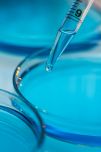
Formulation Development

Formulation Development
Products

Information
Within early development, there are a variety of different challenges that hinder a molecule's ability to progress to the next phase such as complex formulation. The complexity of formulation development has been on the rise, which is driven by a variety of different factors including: Orphan drugs: This market is projected to grow at 13% CAGR from 2020-2024 mRNA therapeutics: Prior to the COVID-19 Pandemic, the global mRNA therapeutics market was estimated to reach ~3B by 2026 Repurposed drugs: Costs of bringing a repurposed drug to market have been estimated to be US$300 million on average, compared with an estimated ~$2-3 billion for a new chemical entity. Thermo Fisher's team of experts can help you solve the most complex formulation challenges through a variety of services including: ? Pref...
Main Categories
Contract Services - Analytical & Lab ServicesPharmaceutical Machinery & Technology
All Categories
Contract Services - Analytical & Lab ServicesDrug Formulation (general category)Formulation developmentPharmaceutical Machinery & Technology
Supplied from
United States
